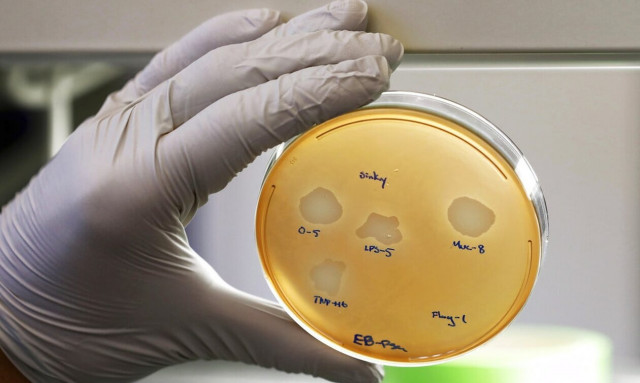
Αυξάνονται οι θάνατοι από το βακτήριο Vibrio vulnificus στις ΗΠΑ

ΛΟΙΜΩΞΗ

Ιός κοξάκι: Αύξηση περιστατικών στη χώρα μας - Προληπτικά μέτρα συστήνει ο ΕΟΔΥ
ΥΓΕΙΑ
·
23.11.2023 - 15:13
Από τα μέσα Σεπτεμβρίου καταγράφεται αύξηση των λοιμώξεων από ρινοϊούς/εντεροϊούς, καθώς και των λοιμώξεων από ιούς κοξάκι - Δεν ενδείκνυται ως μέσο πρόληψης το κλείσιμο σχολικής…

Ανησυχία για τον φονικό μύκητα «Candida Auris» - 122 θάνατοι σε τρία χρόνια
ΕΛΛΑΔΑ
·
22.09.2023 - 21:34
Candida Auris: Σε εφαρμογή το σχετικό πρωτόκολλο της επιτροπής λοιμώξεων για τη γυναίκα στα Χανιά που νοσηλεύεται σε απομόνωση
Αυξάνονται οι θάνατοι από το βακτήριο Vibrio vulnificus στις ΗΠΑ
ΥΓΕΙΑ
·
22.09.2023 - 12:03
«Καμπανάκι» από τα Κέντρα Ελέγχου Νοσημάτων των ΗΠΑ για λοιμώξεις από το επικίνδυνο βακτήριο Vibrio vulnificus.

Παγκόσμια Ημέρα Ηπατίτιδας: Οι τρεις τύποι ιών που προκαλούν χρόνιες λοιμώξεις
ΥΓΕΙΑ
·
28.07.2023 - 07:16
Η 28η Ιουλίου έχει καθιερωθεί ως Παγκόσμια Ημέρα Ηπατίτιδας.

Ώρες αγωνίας για Ρομάριο - Εσπευσμένα στο νοσοκομείο - Σταθερή αλλά κρίσιμη η κατάστασή του
ΠΟΔΟΣΦΑΙΡΟ
·
15.07.2023 - 09:04
Εσπευσμένα σε νοσοκομείο του Ρίο Ντε Τζανέιρο εισήχθη ο Ρομάριο με την κατάστασή του να είναι κρίσιμη, αλλά σταθερή.

Στο νοσοκομείο η Ευρυδίκη Παπαδοπούλου
LIFESTYLE
·
08.07.2023 - 23:10
Στο νοσοκομείο με λοίμωξη η Ευρυδίκη Παπαδοπούλου

Μαντόνα: Της χορηγήθηκε ένεση με φάρμακο για υπερβολική δόση ναρκωτικών
ΚΟΣΜΟΣ
·
07.07.2023 - 12:42
Η Μαντόνα, βρέθηκε μια «ανάσα» από τον θάνατο

Μαντόνα: Η υγεία της παραμένει κρίσιμη - Οι μάνατζερ προετοικάστηκαν για το ενδεχόμενο θανάτου της
ΚΟΣΜΟΣ
·
06.07.2023 - 09:33
«Η Μαντόνα δεν έχει συζητήσει με κανένα άτομο του στενού περιβάλλοντός της για την περιοδεία, καθώς ακόμα αναρρώνει», αναφέρει επίσης το TMZ.

Ανησυχία για την κατάσταση της υγείας της Μαντόνα - Αναβλήθηκε η παγκόσμια περιοδεία της
ΚΟΣΜΟΣ
·
29.06.2023 - 06:44
Η Μαντόνα εισήχθη προ ημερών σε ΜΕΘ εξαιτίας σοβαρής λοίμωξης.

Λένα Μαντά: Σοβαρή περιπέτεια υγείας για τον σύζυγό της - «Μελάνισαν τα ακροδάχτυλά του»
LIFESTYLE
·
22.06.2023 - 18:48
Όπως είπε η συγγραφέας, ο συζυγός της λόγω σοβαρής λοίμωξης χρειάστηκε να νοσηλευτεί στο νοσοκομείο για αρκετές ημέρες, ωστόσο πλέον έχει επιστρέψει στο σπίτι.

Στρεπτόκοκκος - Σπύρος Μαζάνης: «Δεν χρειάζεται πανικός» - Συμπτώματα και μετάδοση
ΕΛΛΑΔΑ
·
14.06.2023 - 08:19
Ο Σπύρος Μαζάνης, παιδίατρος, μίλησε σχετικά με τον στρεπτόκοκκο.

Σε χαμηλό ποσοστό ο μύκητας Candida Auris στα ελληνικά νοσοκομεία - Πόσο πρέπει να ανησυχούμε
ΥΓΕΙΑ
·
01.04.2023 - 15:08
Το αμερικανικό CDC, χαρακτήρισε πρόσφατα τον αναδυόμενο ενδονοσοκομειακό μύκητα ως επείγουσα απειλή, καθώς εξαπλώνεται με ανησυχητικούς ρυθμούς.

Κορονοϊός και εγκυμοσύνη: Μεγαλύτερος κίνδυνος νευροαναπτυξιακών διαταραχών στα αγόρια
ΥΓΕΙΑ
·
23.03.2023 - 17:43
Ο κορονοϊός κατά την εγκυμοσύνη συνδέεται με μεγαλύτερο κίνδυνο νευροαναπτυξιακών διαταραχών στα αρσενικά βρέφη, σύμφωνα με νέα μελέτη.

Στην εντατική ο Ανδρέας Μικρούτσικος - Νοσηλεύεται σε σοβαρή κατάσταση
ΕΛΛΑΔΑ
·
24.02.2023 - 10:51
«Είναι δύσκολα ακόμα. Με πήρε ο γιατρός πριν, σε δύο ώρες θα ξέρουμε περισσότερα αλλά είναι δύσκολα πάλι. Είναι αισιόδοξοι», ανέφερε η Έλενα Μαστραγγελή για…

Έξαρση των λοιμώξεων αναπνευστικού στην Ελλάδα - Μέτρα προστασία για το γιορτινό τραπέζι
ΥΓΕΙΑ
·
17.12.2022 - 08:43
Αυξητική τάση καταγράφουν οι υγειονομικές αρχές της Ελλάδας στη διασποράς της εποχικής γρίπης και της λοίμωξης RSV, ενώ ξεκάθαρα σταθερή είναι η κυκλοφορία του SARS-CoV-2.

Μικροβιακή αντοχή: Μία από τις 10 κορυφαίες παγκόσμιες απειλές
ΦΑΡΜΑΚΟ
·
15.11.2022 - 16:50
Κάθε χρόνο, 33.000 άνθρωποι πεθαίνουν από λοίμωξη που οφείλεται σε βακτήρια ανθεκτικά στα αντιβιοτικά.

Μελέτη: Οι συχνές σοβαρές λοιμώξεις αυξάνουν τον κίνδυνο για Αλτσχάιμερ και Πάρκινσον
ΚΟΣΜΟΣ
·
17.09.2022 - 03:20
Οι επαναλαμβανόμενες σοβαρές λοιμώξεις (από ιούς, βακτήρια και άλλους παθογόνους μικροοργανισμούς) σχετίζονται με αυξημένο κίνδυνο ένας άνθρωπος να διαγνωστεί στη συνέχεια με κάποια νευροεκφυλιστική πάθηση,…

Ιός Δυτικού Νείλου: 13 τα κρούσματα στη χώρα μας
ΥΓΕΙΑ
·
27.07.2022 - 17:21
Μέτρα προφύλαξης κατά των κουνουπιών συστήνει ο Εθνικός Οργανισμός Δημόσιας Υγείας (ΕΟΔΥ).

Λέπρα: Απόλυτα θεραπεύσιμη με κοινά αντιβιοτικά
ΥΓΕΙΑ
·
31.05.2022 - 14:49
Η Ελληνική Δερματολογική και Αφροδισιολογική Εταιρεία (ΕΔΑΕ), με αφορμή το κρούσμα λέπρας που εντοπίστηκε στη χώρα μας, με την ασθενή να νοσηλεύεται στο Πανεπιστημιακό Νοσοκομείο…

Candida Auris: Τρεις έως τέσσερις θάνατοι στην Πάτρα από τον μύκητα - Τι αναφέρει το CDC
ΥΓΕΙΑ
·
10.05.2022 - 04:30
Ανησυχία έχει προκαλέσει στους ειδικούς ο πολυανθεκτικός μύκητας Candida Auris, ο οποίος εντοπίζεται στα νοσοκομεία, προκαλώντας λοιμώξεις. Η πρόεδρος του Ιατρικού συλλόγου Πάτρας Άννα Μαστοράκου γνωστοποίησε…

Συναγερμός στην Πάτρα: Τέσσερις νεκροί από τον φονικό μύκητα Candida Auris
ΕΛΛΑΔΑ
·
09.05.2022 - 23:00
Πάτρα: Τέσσερις νεκροί από τον φονικό μύκητα Candida Auris - Οι ειδικοί κρούουν τον κώδωνα του κινδύνου.

Candida Auris: Τρεις ειδικοί απαντούν σε 5 ερωτήματα – Γιατί μας προβληματίζει ο φονικός μύκητας
ΥΓΕΙΑ
·
09.05.2022 - 07:43
Η εμφάνιση πολυανθεκτικών μικροβίων, όπως η candida auris, είναι μια ατέρμονη απειλή και παραμένει μια σημαντική πρόκληση στη σύγχρονη θεραπεία και στον έλεγχο των λοιμώξεων

ECDC: Βρέθηκαν κρούσματα ηπατίτιδας Ε από τρωκτικά στην Ευρώπη
ΚΟΣΜΟΣ
·
12.03.2022 - 10:11
Μια πρόσφατη μελέτη του ECDC αναφέρεται στον κίνδυνο από την εμφάνιση της ηπατίτιδας Ε.

Οι μικροβιακές λοιμώξεις σκοτώνουν πιο πολύ από το AIDS - 1,27 εκατ. άνθρωποι πέθαναν το 2019
ΥΓΕΙΑ
·
20.01.2022 - 11:09
Η μικροβιακή αντοχή στα αντιβιοτικά θα ευθύνεται για 10 εκατομμύρια θανάτους ετησίως νωρίτερα από το 2050, όπως είχε αρχικά εκτιμηθεί.

ECDC: Από τα παιδιά 0-17 ετών με Covid-19 το 1,2% χρειάζονται νοσηλεία, κυρίως εκείνα έως δύο μηνών
ΥΓΕΙΑ
·
17.12.2021 - 09:10
Κορονοϊός - Όλες οι ειδήσεις: Έρευνα του ECDC δείχνει ποιες ηλικιακές ομάδες παιδιών κάτων των 17 ετών κινδυνεύουν περισσότερο με το ενδεχόμενο νοσηλείας.






